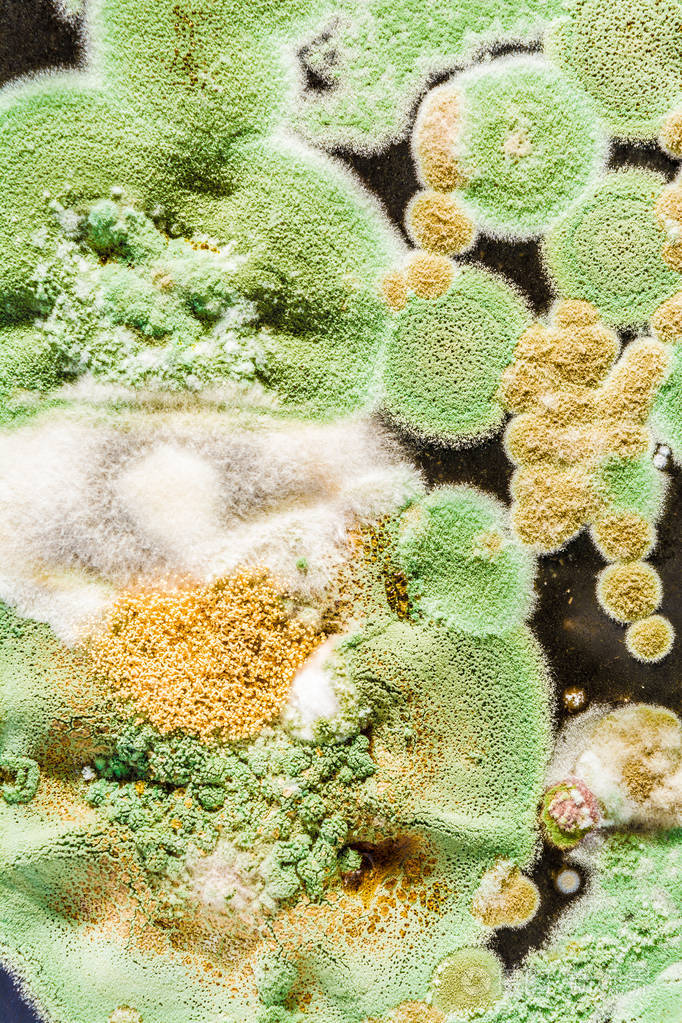
黑色背景上绿色霉菌和真菌的纹理微生物学

真菌图片

真菌,蘑菇,森林的地面,森林
图片尺寸4320x3240
黑色背景上绿色霉菌和真菌的纹理微生物学
图片尺寸682x1023
这几组图片都是真菌感染性皮肤病
图片尺寸1280x756
microsporia在手臂的皮肤上的真菌
图片尺寸678x1024
真菌小蘑菇图片壁纸(18/23)
图片尺寸1920x1200
真菌
图片尺寸383x450
发霉的真菌
图片尺寸1024x1024
真菌小蘑菇图片唯美的真菌世界
图片尺寸600x450
灰指甲和手足癣的真菌长什么样
图片尺寸1080x691
真菌
图片尺寸600x450
蘑菇, 真菌, 木头, 自然, 毒物, 植物群, 孢子, 苔藓
图片尺寸3100x2325
山中珍宝大型真菌4
图片尺寸3888x2592真菌图片欣赏
图片尺寸640x480
大讲堂真菌图片小札(一)
图片尺寸1200x1200
常见真菌皮肤病图片常见真菌皮肤病症状及图片
图片尺寸478x336
皮肤性病科图谱真菌性皮肤病体癣
图片尺寸3264x2448
日光, 真菌, 自然, 蘑菇, 有机体, 地面, 细节
图片尺寸4058x2705
高原生物——真菌篇
图片尺寸2981x2000
大讲堂真菌图片小札(一)
图片尺寸999x1332微观下的蘑菇真菌 |steve axford
图片尺寸600x450
猜你喜欢:显微镜下真菌的图片人体真菌图片真菌图谱淋病的症状图片真菌细胞图片什么是真菌真菌孢子食用真菌图片真菌细菌图片真菌和霉菌的区别图片感染真菌图片真菌图片卡通皮肤感染真菌图片真菌的基本结构图简图细菌真菌指甲真菌感染图片真菌的细胞结构图脚气真菌图片 显微镜女性真菌感染图片展示各种真菌图片大全细胞真菌感染图片真菌水泡型脚气图片人身上真菌感染图片脚上长真菌图片真菌显微镜下真菌的形态手上真菌皮肤病对照图白色真菌人皮肤真菌感染大图革兰染色真菌形态图铃木gn250改装复古跃迪电动汽车t70-3配件辽朝国旗那不勒斯队徽梁心今天早安图一个人路人唯美舞乐传奇海东来手机超清4k壁纸 霸气仓库logo图标梢棒图片霹雳蓝天使2